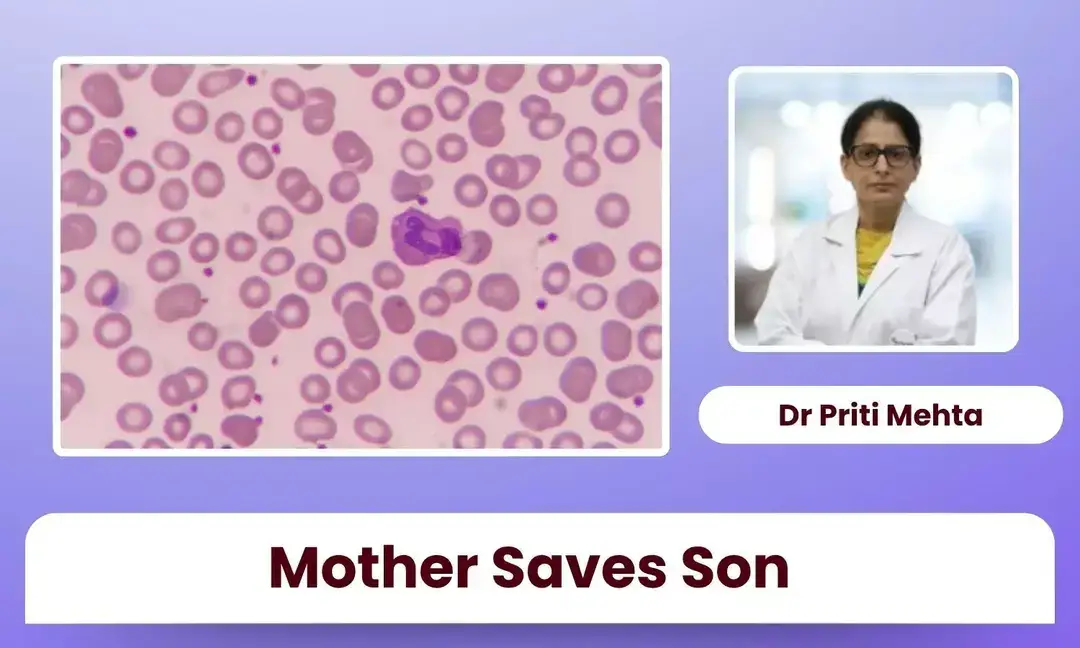
Mother donor saves boy with high-risk leukemia

Periodontist Dr Saumya Saluja writes, Oral hygiene should begin in infancy by cleaning gums before tooth eruption, followed by brushing once the first tooth appears. Understanding this can help you build a routine that protects your child's smile long before problems begin. The habit matters more than the number of teeth.


Sleeping for 11 minutes more each night can significantly reduce likelihood of a heart attack, a global study published in European Journal of Preventive Cardiology said. The researchers also found that doing 4.5 additional minutes of brisk walking and eating an extra 50 grams of vegetables each day could also help people avoid major cardiovascular events by about 10%.


I’d tried every diet and app before, but nothing stuck. Then I discovered Zylo AI. Instead of guessing, I started tracking my meals with a single photo. Zylo instantly showed me calories, protein, and nutrients no manual logging, no confusion.
Slowly, I built better habits and stayed consistent. In just months, I lost 26 kgs and gained real confidence. Zylo didn’t just track my food — it changed how I live.
Track smarter. Eat better and the best part its Free Calorie Tracker

India's drug regulator has stepped up monitoring of unauthorised sale and promotion of GLP-1-based weight loss drugs. Acting on concerns over their easy availability, authorities inspected 49 entities, including online pharmacy warehouses, wholesalers, retailers, and wellness clinics. "Misuse of weight loss drugs without clinical oversight can lead to severe health complications," government said.


Doctors in Manipal Hospital in Delhi successfully treated a 14-year-old girl with a rare, aggressive gastroesophageal cancer that left her unable to swallow. After chemotherapy, she underwent advanced robotic surgery to remove the tumour. The teen is now recovering well. The case highlights the importance of early diagnosis and recognising symptoms like dysphagia.


On World TB Day, several Chief Ministers, including UP CM Yogi Adityanath, stressed that tuberculosis remains a major public health challenge. They urged people to spread awareness, ensure early detection, and follow proper treatment. Leaders called for collective efforts to eliminate TB and achieve the goal of a TB-free India.


Middle East crisis is having a cascading effect on India’s pharmaceutical and medical devices industries. Disruptions in global shipping and crude has hampered supply chains and driven up costs. Industry insiders say higher prices for active pharma ingredients, packaging materials and transport will push up medicine costs. They warn that if this continues, it could halt production and cost jobs.


I used to struggle with tracking my meals and staying consistent. Then I found Zylo AI, it made calorie tracking effortless. Just a quick photo, and I knew exactly what I was eating. I have Lost over 12 Pounds (Kgs) in 30 days.
Over time, I learned my habits, made smarter food choices, and finally reached my goal weight. Zylo didn’t just count calories; it guided me toward balance and progress.
Start your journey with Zylo AI track smarter, live better.

Tuberculosis is rising among young professionals, with a cough lasting over two weeks as a key warning sign, says Dr Lalit Mishra, Consultant Chest Physician. Urban stress, pollution, and self-medication delay diagnosis. On World TB Day, experts stress early detection, as TB is treatable if caught in time.


Dr Supratim Sen and team saved a five-day-old newborn with a critical congenital heart defect using timely PDA stenting. The baby had dangerously low oxygen levels and required urgent intervention. Following stabilisation and a complex procedure, the newborn recovered well, highlighting the importance of early diagnosis and coordinated cardiac care.

Dr Priti Mehta reported a life-saving case where a mother donated stem cells to her 12-year-old son with high-risk leukemia. After progressing to AML blast crisis, he underwent a complex haploidentical transplant. The child achieved full remission with no major complications, highlighting the success of advanced paediatric bone marrow transplant techniques.


Union Minister Jitendra Singh said India is emerging as a global pharma and medtech hub, boosting GDP growth. He highlighted advances in indigenous manufacturing, vaccines, and medical devices. With schemes like PRIP and policy support, India aims to expand innovation, reduce import dependence, and strengthen its position in the global healthcare ecosystem.
